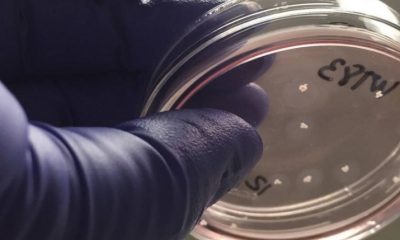
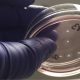

El técnico blanco no pudo ganar en el feudo bilbaíno en su anterior etapa en el Madrid y en ambos casos se dejó puntos vitales para...

Científicos australianos han enseñado a neuronas humanas en el laboratorio a jugar al clásico videojuego ‘Pong’. Lo han conseguido en solo 5 minutos, mucho más rápido...



Letizia se ha desplazado hasta la capital de Guipúzcoa para inaugurar la Reunión Anual de directores del Instituto Cervantes. Esperemos que os guste este look de la Reina...



La variante ómicron se está «propagando a la velocidad de un rayo» en Europa y probablemente se convierta en la cepa dominante en Francia a principios...



El Barça está trabajando a marchas forzadas para intentar reforzar la parcela ofensiva del equipo en el mercado de enero. El delantero que cuenta con más opciones de...



El joven diputado de izquierda Gabriel Boric, abanderado del Frente Amplio y el Partido Comunista. El candidato progresista, de 35 años, obtiene el 55,87% de los votos,...



Las selecciones sudamericanas podrán participar en la Liga de Naciones a partir de 2024, afirmó el viernes el polaco Zbigniew Boniek, vicepresidente de la UEFA. »...



Con el Covid.La detección de la variante ómicron en Sudáfrica a fines de noviembre supuso la aparición de nuevas incógnitas con respecto a la pandemia para...



El venezolano de los Tigres de Detroit, Miguel Cabrera, es una referencia en las Grandes Ligas – MLB y tanto es así, que es el pelotero más buscado por los fanáticos en...



El técnico argentino quiere contar con él a partir de enero en Europa. Son varios los jugadores que a día de hoy están en la rampa...
Comentarios